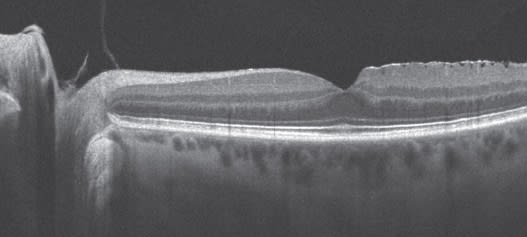

Retina Imaging and the Cataract Surgeon
Here's how routine imaging with spectral domain OCT can help ensure optimal outcomes in cataract surgery.

By Paul E. Tornambe, MD
Spectral domain OCT is invaluable for preoperative assessment of patients with cataracts, particularly if premium IOLs will be implanted. Recognizing macular pathology prior to cataract surgery ensures:
• Guidance regarding the order of procedures (cataract versus retina)
• Appropriate IOL selection
• Realistic visual outcomes with no post-op surprises
The bottom line: cataract surgeons have to know the macula is perfect before implanting a premium IOL, and patients need to know the macula is perfect before receiving a premium IOL. Here are common scenarios.
Important Pre-op Findings
The more common conditions the cataract surgeon should be concerned about are vitreomacular traction syndrome and epiretinal membranes (ERMs), whether they are visually significant or not, because after cataract surgery, the vitreous may partially separate and cause more traction, and the ERM can become visually significant. That is not to say, however, that a premium IOL would be contraindicated in the presence of a minor epiretinal membrane because most are not visually significant, but certainly it should be documented preoperatively. These membranes can be quite subtle, but with Cirrus SD-OCT B-scan (Figure 1) and C-scan, diagnosis is simple. The cataract surgeon may decide to send the scan to the retina specialist to determine whether or not the ERM is visually significant, and to discuss which type of IOL should be implanted, and if the macular problem should be addressed before or after the cataract surgery.
Figure 1. Determining if an epiretinal membrane is present before cataract surgery is an important step in patient management and can be done easily with Cirrus HD-OCT.
Vitreomacular traction syndrome can be difficult even for a retina specialist to diagnose without SD-OCT. Let's say a patient has reduced vision and a moderate cataract, but the vision seems to be just a little bit worse than the cataract surgeon would expect it to be. There is no macular degeneration, no macular hole and no macular pucker. There might be a subtle reddish-yellowish change in the fovea. You scratch your head and say what's going on with this patient? With Cirrus HD-OCT, it is obviously vitreomacular traction syndrome (Figure 2). You may also have a patient who appears to have dry macular degeneration, but if SD-OCT shows fluid and the patient is not diabetic, almost always the patient has an occult choroidal neovascular membrane that needs to be addressed before the cataract is removed.

Figure 2. Vitreomacular traction syndrome can be especially difficult to diagnose without SD-OCT.
Other common entities that may be encountered during a preoperative assessment for cataract include macular hole, macular pucker and diabetic macular edema (Figures 3-5). ■

Figures 3 to 5. During preoperative assessment watch for conditions such as macular hole (top image), macular pucker (center) and diabetic macular edema (bottom).
| Cataract-Retina Consult |
|---|
| I usually advise patients, especially those over the age of 50 who are at risk of developing a vitrectomy-related cataract within 2 years of vitreous surgery, to have their existing cataract removed before undergoing macula surgery. If their visual needs are satisfied after cataract surgery, they do not need macula surgery, which happens in about 20% of cases. Most of the time, however, patients return to us because the macular disease is visually significant, which we predicted preoperatively. When a cataract patient will need retinal surgery, I prefer to implant a monofocal lens. I ask the surgeon to use as large an optic as possible, not to use a silicone IOL, which fogs up during an air-fluid exchange, and to place a temporary suture in the corneal incision wound, which I usually remove at the end of the vitrectomy. We have found complications can develop from the recent cataract wound during retinal surgery.1 Scleral depression in the same quadrant as the clear corneal wound can cause a wound leak and sometimes iris prolapse. Pseudophakia allows for a more complete vitrectomy. I can address the anterior vitreous base without worrying about bumping the lens, and especially if I am repairing a macular hole, I can place a bigger SF6 gas bubble in the eye, which lasts a bit longer than it does in a phakic eye. This is important because I do not position the patient face down at any time following vitrectomy for a macular hole. Furthermore, it is easier for a cataract surgeon to remove a lens before a vitrectomy than after a vitrectomy. It is a win-win for both of us. REFERENCE1. Wong RW, Kokame GT, Mahmoud TH, Mieler WF, Tornambe PE, McDonald HR. Complications associated with clear corneal cataract wounds during vitrectomy. Retina. 2010;30:850-855. |
| Premium IOLs and Macula Surgery |
|---|
| Both accommodative and multifocal IOLs present specific challenges for retina surgeons. The optic of an accommodative lens is smaller than a monofocal lens. During macula surgery—membrane peeling, for example—as the vitrectomy instrument moves toward the edge of the lens, it seems to jump into the field. To minimize this effect, the eye must be positioned so the target tissue is as close to the central visual axis of the lens as possible. If the pathology is off to one side or the other at the junction of the visual axis of the edge of the IOL, it can be quite challenging to work on the macular pathology. Multifocal IOLs, which are basically concentric rings of different refraction gradients, also present challenges in retina surgery. For reasons I do not completely understand, the amount of light that comes back to the surgeon's eye to operate is decreased, requiring a higher-intensity endoillumination, which increases the risk for macular phototoxicity. When performing macula surgery, particularly peeling the ILM, the surgeon needs as crisp a view into the eye as possible. The benefit of multifocal IOLs for patients is that they provide good vision at all distances, however, the vision is not quite as crisp as it would be with a monofocal lens. The surgeon's view into the eye through the lens is the same as the patient's view out of the lens, and unless the surgeon views the retinal pathology through the center of the IOL, the surgeon's view is not crisp. I have been able to demonstrate this using the Optos ultra-widefield image scan. What you see is a central clear area, which is the image taken through the center of the IOL. Moving more peripherally, the retina is darker and not as clearly visible. Even more compelling is an image generated by the Cirrus HD-OCT that looks like a red-free photograph but is actually an LSO (line scanning ophthalmoscope) image. This image may actually show the refraction gradients of the IOL superimposed on the retina, demonstrating how the IOL rings may interfere with the surgeon's view. |
Dr. Tornambe is in private practice in San Diego, Calif. He is Director of the San Diego Retina Research Foundation and is a consultant to Carl Zeiss Meditec. He can be reached at TornambePE@aol.com.








